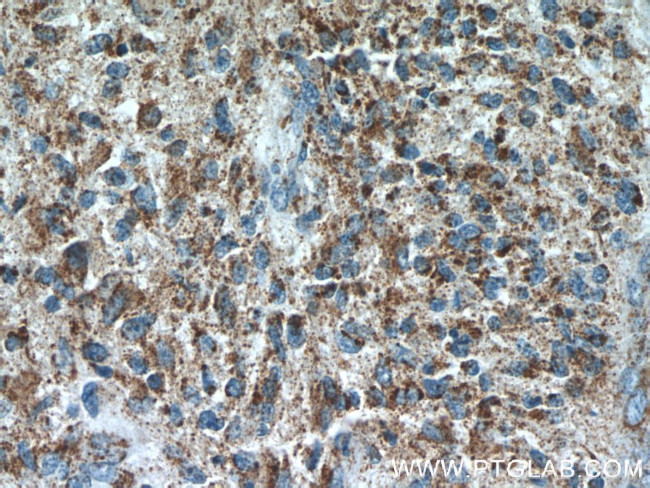
CHURC1 Antibody in Immunohistochemistry (Paraffin) (IHC (P))
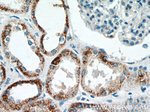
CHURC1 Antibody in Immunohistochemistry (Paraffin) (IHC (P))

Search
Proteintech
CHURC1 Polyclonal Antibody
{{$productOrderCtrl.translations['antibody.pdp.commerceCard.promotion.promotions']}}
{{$productOrderCtrl.translations['antibody.pdp.commerceCard.promotion.viewpromo']}}
{{$productOrderCtrl.translations['antibody.pdp.commerceCard.promotion.promocode']}}: {{promo.promoCode}} {{promo.promoTitle}} {{promo.promoDescription}}. {{$productOrderCtrl.translations['antibody.pdp.commerceCard.promotion.learnmore']}}
产品信息
12247-1-AP
种属反应
宿主/亚型
分类
类型
抗原
偶联物
形式
浓度
规格
纯化类型
保存液
内含物
保存条件
运输条件
产品详细信息
The MW of this protein is 13 kDa, and 12247-1-AP specifically recognizes the 13 kDa protein.
Immunogen sequence: MCGDCVEKE YPNRGNTCLE NGSFLLNFTG CAVCSKRDFM LITNKSLKEE DGEEIVTYDH LCKNCHHVIA RHEYTFSIMD EFQEYTMLCL LCGKAEDTIS ILPDDPRQMT LLF (1-112 aa encoded by BC020550)
靶标信息
Transcriptional activator that mediates FGF signaling during neural development. Plays a role in the regulation of cell movement. Does not bind DNA by itself.
仅用于科研。不用于诊断过程。未经明确授权不得转售。
篇参考文献 (0)
生物信息学
蛋白别名: Protein Churchill; unnamed protein product
基因别名: 1700030P15Rik; C14orf52; CHCH; CHURC1; My015
UniProt ID: (Human) Q8WUH1, (Mouse) Q6DG52
Entrez Gene ID: (Human) 91612, (Mouse) 211151, (Rat) 299154